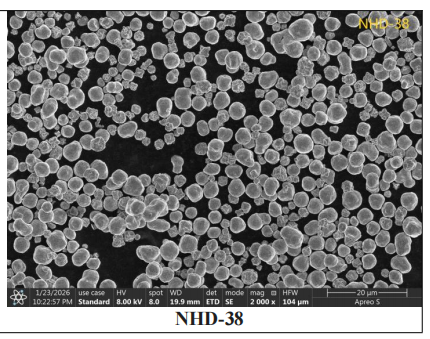
图片

NHD高致密球形镍粉:光伏电子浆料+精密制造核心基材,性能领先
NHD高致密球形镍粉:光伏电子浆料+精密制造核心基材,性能领先
NHD系列高致密球形镍粉,以超高致密、完美球形、低收缩、易包覆等核心优势,成为高端材料升级换代优选。

产品核心特点
光滑规整球形:颗粒圆润、表面平整,流动性与分散性佳
超高振实密度:>4.5 g/cm3,填充度高、空隙少
黄金粒径区间:2–10 μm,适配高端浆料与精密成型
高纯度高品质:镍含量≥99.5%,杂质低、性能稳定
低收缩低吸附:烧结变形小,助剂用量更少
与传统镍粉对比
|
对比项目 |
|
传统不规则雾化镍粉 |
电解树枝状/纤维状镍粉 |
|
形貌与流变性 |
球形,流动顺滑、休止角优异 |
不规则,流动中等–较差 |
树枝/纤维,易缠绕、桥接、堵塞 |
|
振实密度 |
极高,可达理论密度60% |
较低,空隙率高 |
极低,结构疏松 |
|
分散性 |
极佳,分散剂用量少、不易团聚 |
较差,孔隙多、吸附高 |
极差,比表面积大、吸附量大 |
|
烧结收缩 |
极低、各向同性、不翘曲 |
较高、各向异性、易变形 |
极高、易收缩塌陷 |
|
镀银包覆 |
银层均匀致密,超薄即可全包覆 |
包覆不均,银耗偏高 |
包覆困难,银层易破损 |
|
制备工艺 |
羰基热分解 / 等离子球化 |
高压水/气雾化 |
电解沉积 / 液相还原 |
产品关键技术指标
|
|
形貌 |
松装密度(g/cm3) |
振实密度(g/cm3) |
D50(μm) |
镍含量 |
|
NHD-25 |
球形 |
2~3 |
4.5~5.0 |
≤3.0 |
≥99.5% |
|
NHD-38 |
球形 |
3~4 |
4.7~5.2 |
≤5.5 |
≥99.5% |
|
NHD-510 |
球形 |
3~4 |
4.8~5.3 |
≤6.0 |
≥99.5% |
|
NHD-614 |
球形 |
3~4 |
4.9~5.5 |
≤7.0 |
≥99.5% |
电镜图

NHD 高致密球形镍粉在镀银包覆中的应用
NHD 系列镍粉是银包镍导电填料的理想基材。球形光滑表面让银晶核均匀成核生长,可形成致密连续银层,仅需100–200nm 超薄镀层、银含量 6–15wt%即可实现100% 完全包裹。既保留银的高导电与可焊性,又发挥镍的耐高温、抗氧化优势,大幅降低银耗成本,广泛用于光伏 HJT 电极、电子浆料、导电胶、电磁屏蔽材料等高端场景。
NHD 高致密球形镍粉在光伏与电子浆料中的应用
NHD系列镍粉是低温HJT银包镍导电填料的理想基材,在光伏与电子浆料领域优势突出:
1、高流变与高填充
高振实密度+规整球形,赋予浆料优异流平性、印刷性与填充密度,让导电通路更连续、膜层更致密。
2、超薄银层完美包覆
表面平滑,银晶核可均匀成核、均匀生长,形成致密保形的连续银层。
银层厚度:100–200 nm
银含量:6–15 wt%
即可实现100%完全包裹镍核,在保证高导电性能的同时,大幅降低银浆使用成本。
3、适配多类高端浆料
适用于:
低温HJT光伏电池电极浆料
高端电子导电浆料、厚膜电路浆料
柔性电子、导电胶、导电油墨
MLCC多层陶瓷电容内电极材料

全场景应用覆盖
1、粉末冶金MIM
高精密MIM结构件、医疗器械、汽车电子、通信零部件,高装载量喂料、低收缩精密成型。
2、其他高端场景
电磁屏蔽与吸波材料:球形粉体填充均匀,提升屏蔽效能与加工流动性
微电子封装与导热材料:高致密低孔隙,提升导热效率与器件可靠性
金刚石工具/硬质合金:作为粘结相,提升烧结致密性与整体强度
导电复合材料:塑料/橡胶导电改性,低添加量即可达到导电要求
催化剂载体:结构稳定、比表面积适中,适配各类催化反应
高温合金与3D打印:球形高流动性,适配粉体铺展与成型精度
导电涂层与防腐涂层:提升涂层导电性、致密性与耐候性
安特普纳公司专注高性能金属粉体材料供应,为光伏、电子、粉末冶金、微电子封装等领域提供稳定可靠的粉体解决方案。